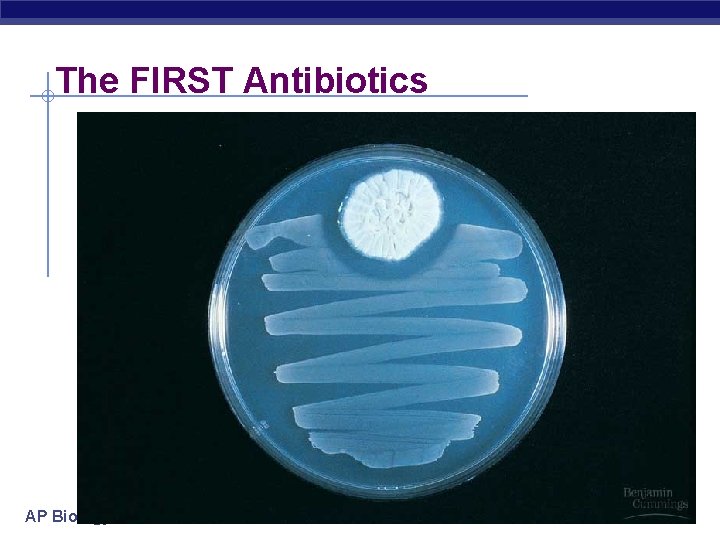

Kingdom Fungi Domain Eukarya Domain Bacteria AP Biology

Kingdom: Fungi Domain Eukarya Domain Bacteria AP Biology Domain Archaea Domain Eukarya 2007 -2008 Common ancestor

General characteristics § Classification criteria eukaryotes u heterotrophs u § feed by absorption u mostly multicellular § except unicellular yeasts u cell wall § chitin w rigid polysaccharide u AP Biology sexual & asexual reproduction

Fungal Structure § Fungal body u mycelium § thread-like cells § hyphae § Cells u multiple nuclei § Cell wall u chitin § just like crab shells AP Biology

Internal structure § Eukaryotic cells u long, thread-like cells § filamentous u incomplete divisions between cells § septum u multiple nuclei Aaaaah, structure–function relationship! AP Biology chitin cell wall septum pore nuclei

Modes of Nutrition § Heterotrophic fungal hypha secrete digestive enzymes u feed by absorption u § parasites w feeding on living creatures plant cell § predators membrane w paralyzing prey § decomposer w breakdown dead remains AP Biology Fungi live IN their food! It’s like you living in Chocolate cake! plant cell wall

Fungal Diversity y m o idi tr hy C AP Biology ta o c y m go Zy Fungi ta o c o ta o c my Ba i d i s ta o c As c y m o

Ecological Roles § Decomposers u recycle nutrients § Symbiotic Relationships u lichen § fungi + algae w cyanobacteria or green algae § pioneer species in ecosystems § makes soil from bare rock u Lichens are fungi that have discovered agriculture! mycorrhizae § fungi + plants § enables plants to absorb more water AP Biology

Mycorrhizae § Critical role in plant growth u extends water absorption of roots without mycorrhizae Endomycorrhiza AP Biology Ectomycorrhiza with mycorrhizae

Reproduction § Asexual u budding in yeast § Sexual u spores § spread by wind u joining of + & – haploid spores AP Biology

Zygomycete (Bread Mold) Life Cycle spores (haploid) mating strain hypha sporangium MEIOSIS (2 n) diploid AP Biology (n) haploid FUSION of + and – gametangia mating strain

Basidiomycete Life Cycle fruiting body gills lined with basidia basidium (n + n) dikaryotic 2 n (diploid) (n) haploid strain AP Biology FUSION of and hyphae strain zygote MEIOSIS spores

Fairy Rings AP Biology
The FIRST Antibiotics AP Biology

Any Questions? ? AP Biology 2007 -2008
- Slides: 14